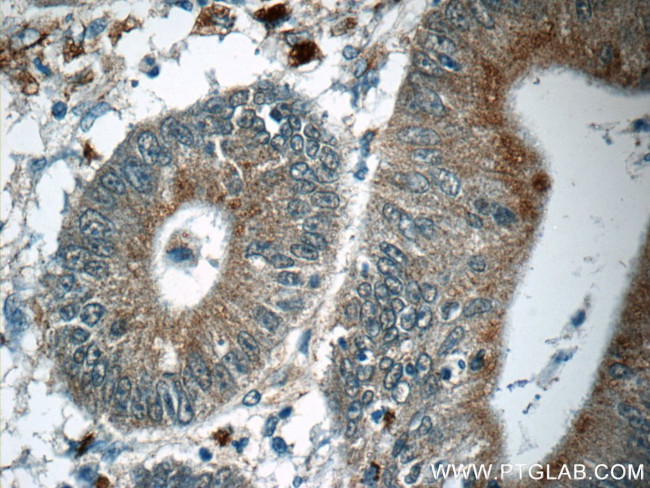
MUTYH Antibody in Immunohistochemistry (Paraffin) (IHC (P))

Search
Proteintech
MUTYH Polyclonal Antibody
{{$productOrderCtrl.translations['antibody.pdp.commerceCard.promotion.promotions']}}
{{$productOrderCtrl.translations['antibody.pdp.commerceCard.promotion.viewpromo']}}
{{$productOrderCtrl.translations['antibody.pdp.commerceCard.promotion.promocode']}}: {{promo.promoCode}} {{promo.promoTitle}} {{promo.promoDescription}}. {{$productOrderCtrl.translations['antibody.pdp.commerceCard.promotion.learnmore']}}
产品信息
19650-1-AP
种属反应
宿主/亚型
分类
类型
抗原
偶联物
形式
浓度
规格
纯化类型
保存液
内含物
保存条件
运输条件
产品详细信息
Immunogen sequence: MPRTAETLQ QLLPGVGRYT AGAIASIAFG QATGVVDGNV ARVLCRVRAI GADPSSTLVS QQLWGLAQQL VDPARPGDFN QAAMELGATV CTPQRPLCSQ CPVESLCRAR QRVEQEQLLA SGSLSGSPDV EECAPNTGQC HLCLPPSEPW DQTLGVVNFP RKASRKPPRE ESSATCVLEQ PGALGAQILL VQRPNSGLLA GLWEFPSVTW EPSEQLQRKA LLQELQRWAG PLPATHLRHL GEVVHTFSHI KLTYQVYGLA LEGQTPVTTV PPGARWLTQE EFHTAAVSTA MKKVFRVYQG QQPGTCMGSK RSQVSSPCSR KKPRMGQQVL DNFFRSHIST DAHSLNSAAQ (187-535 aa encoded by BC003178)
靶标信息
MYH (mutY homolog (E. coli )) is a DNA glycosylase mismatch repair enzyme that in conjunction with mutM (OGG1), cleaves adenine residues paired with either oxidized (8-hydroxyguanines) or non-modified guanines in order to correct A/G and A/C mismatches. Repair of most modified and mispaired bases in the genome is initiated by DNA glycosylases, which bind and cleave N-glycosyl bonds to initiate base excision repair. MYH is crucial for the avoidance of mutations resulting from oxidative DNA damage. Multiple N-terminal splice variants of MYH exist in mammalian cells. Increasing levels of MYH in A549 cells exposed to oxygen and infrared radiation leads to improvements in cell survival. Biallelic MYH germ-line mutations predispose humans to colorectal adenomas and carcinomas. MYH is abundant in neurons where mitochondrial genomes exposed to reactive oxygen species (ROS) that damage DNA must maintain integrity over the entire mammalian life span.
仅用于科研。不用于诊断过程。未经明确授权不得转售。
生物信息学
蛋白别名: A/G-specific adenine DNA glycosylase; Adenine DNA glycosylase; adenine-DNA glycosylase; hMYH; MGC4416; mMYH; MutY homolog; mutY homolog (E. coli) isoform MUTYH_1; mutY homolog (E. coli) isoform MUTYH_3; mutY homolog alpha; mutY-like protein; OTTHUMP00000009098; OTTHUMP00000009102; rMYH; RP4-534D1.2; the full-length form type A, 5' region; unnamed protein product
基因别名: 5730495A01Rik; MUTYH; Mutyha; Mutyhalpha; Mutyhb; Mutyhbeta; Mutyhc; MYH
UniProt ID: (Human) Q9UIF7, (Mouse) Q99P21, (Rat) Q8R5G2
Entrez Gene ID: (Human) 4595, (Mouse) 70603, (Rat) 170841